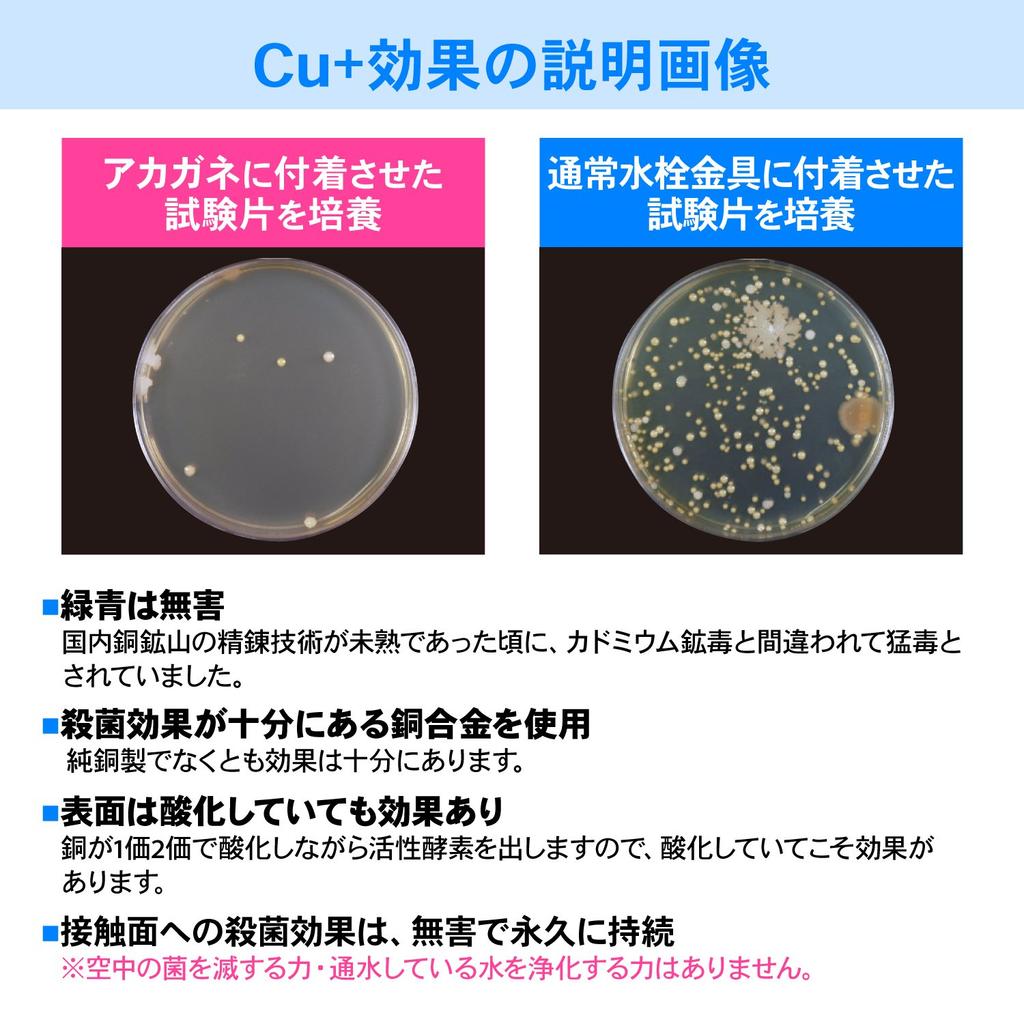
Kakudai Double Mouth Home Faucet 705-014-13

The website doesn't support your browser. Please update your browser or download a different one
Kakudai Double Mouth Home Faucet 705-014-13
Current price
Price €137VAT included

Delivery 11–31 business days

Delivery €4
Returns & refunds
Secure payments







Our support team speaks English
Safety & compliance
Safety & compliance
Description
AniWorld
4.6/88
Similar products

![KVK 2 Handle Mixer Faucet [KM33N3W]](https://img.joomcdn.net/94848cb8d946bbacfdd30e51a6f6b19beeafea6f_100_100.jpeg)








![KVK 2 Handle Mixer Faucet [KM33N3WBN]](https://img.joomcdn.net/b5b9e533943043bb079d82c96f57c3e30e26d1e9_100_100.jpeg)
![KVK Single Shower Plating for Bath [KF5000T]](https://img.joomcdn.net/3e471554016cfd7c79b9826b48603b516e4b0fd6_100_100.jpeg)
